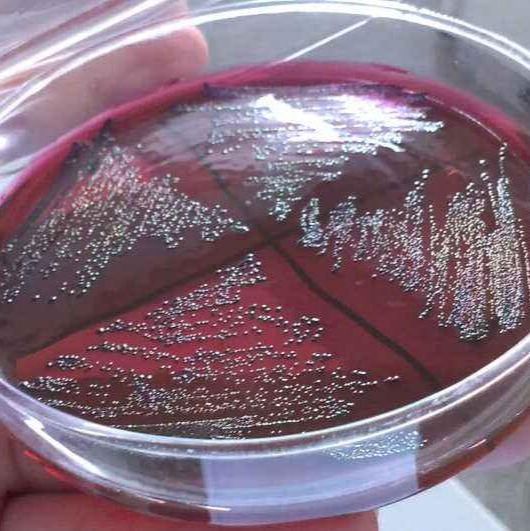
产品封面图

万千商家帮你免费找货
0 人在求购买到急需产品
- 详细信息
- 文献和实验
- 技术资料
- 库存:
35
- 英文名:
SB Medium
- 保质期:
详见说明书
- 供应商:
上海一研
- 保存条件:
低温冷藏
- 规格:
250g
| 产品名称 | SB培养基价格 |
| 英文名称 | SB Medium |
| 货号 | EYJ6746 |
英文名称:SB Medium
产品规格:250g
用途:用于基因工程菌大肠杆菌培养,营养非常丰富。
用法
称取本品 57.0g,加热溶解于 1000ml 蒸馏水中,分装,121℃高压灭菌 15 分钟,备用。
培养基的保存时需注意:
SB培养基价格培养基应存放于冷暗处,建议存放于普通冰箱内。放置时间不宜超过一周,倾注的平板培养基不宜超过3天。产品仅限于科研每批培养基均必须附有该批培养基制各记录副页或明显标签。
培养基(Medium)是供微生物、植物和动物组织生长和维持用的人工配制的养料,一般都含有碳水化合物、含氮物质、无机盐(包括微量元素)以及维生素和水等。有的培养基还含有抗菌素和色素,用于单种微生物培养和鉴定。
培养基由于配制的原料不同,使用要求不同,而贮存保管方面也稍有不同。一般培养基在受热、吸潮后,易被细菌污染或分解变质,因此一般培养基必须防潮、避光、阴凉处保存。对一些需严格灭菌的培养基(如组织培养基),较长时间的贮存,必须放在2~6℃的冰箱内。由于液体培养基不易长期保管,现在均改制成粉末。

培养基按其物理状态可分为固体培养基、液体培养基和半固体培养基三类。
(1)固体培养基。是在培养基中加入凝固剂,有琼脂、明胶、硅胶等。固体培养基常用于微生物分离、鉴定、计数和菌种保存等方面。
用于微生物分离,鉴定,计数。如图,微生物分离成菌落、菌苔。图中为大肠杆菌菌落,是用涂布平板法得到。
用于分离微生物的固体培养基
用于分离微生物的固体培养基
(2)半固体培养基。是在液体培养基中加入少量凝固剂而呈半固体状态。可用于观察细菌的运动、鉴定菌种和测定噬菌体的效价等方面。
用于观察微生物运动特征。如图,左侧试管中微生物不运动,而右侧试管中微生物运动,因而两试管中现象不同
用于观察微生物运动特征的半固体培养基
用于观察微生物运动特征的半固体培养基
(3)液体培养基。液体培养基中不加任何凝固剂。这种培养基的成分均匀,微生物能充分接触和利用培养基中的养料,适于作生理等研究,由于发酵率高,操作方便,也常用于发酵工业。
按培养基组成物质的化学成分区分
根据对培养组成物质的化学成分是否完全了解来区分,可以将培养基分为天然培养基、合成培养基和半合成培养基。
(1)天然培养基。天然培养基是指利用各种动、植物或微生物的原料,其成分难以确切知道。例如培养细菌常用的肉汤蛋白胨培养基:牛肉膏3g,蛋白胨5g,水1000mL。
用做这种培养基的主要原料有:牛肉膏、麦芽汁、蛋白胨、酵母膏、玉米粉、麸皮、各种饼粉、马铃薯、牛奶、血清等。用这些物质配成的培养基虽然不能确切知道它的化学成分,但一般来讲,营养是比较丰富的,微生物生长旺盛,而且来源广泛,配制方便,所以较为常用,尤其适合于配制实验室常用的培养基和大上的培养基。
这种培养基的稳定性常受厂或批号等因素的影响,另外自养微生物一般不能在其上面生长。
(2)合成培养基。产品仅限于科研合成培养基是一类化学成分和数量完全知道的培养基,它是用已知化学成分的化学药品配制而成。例如培养细菌的葡萄糖铵盐培养基:C6H12O60.2%,K2HPO40.7%,KH2PO4 0.3%,Na3C6H5O70.05%,MgSO4·7H2O0.01%,(NH4)2SO40.1%,H2O 100mL。
这类培养基化学成分精确、重复性强,但价格昂贵,而微生物又生长缓慢,所以它只适用于做一些科学研究,例如营养、代谢的研究。
(3)半合成培养基。在合成培养基中,加入某种或几种天然成分;或者在天然培养基中,加入一种或几种已知成分的化学药品即成半合成培养基。例如马铃薯蔗糖培养基等。如果在合成培养基中加入琼脂,由于琼脂中含有较多的化学成分不太清楚的杂质,故也只能算是半合成培养基。这种培养基在实践和实验室中使用最多。
BTA-2 20mg
TrichinellaspiralisIgGAnti-HumanIgG4heavychainantibody[5C7]
TrichinellaspiralisAb(pig)ElisaAnti-Kappalightchainantibody[4G7]
TriCatResearchElisa(Adren./Noradren./Dopamine)Anti-LambdaFreeLightChainantibody[3D12]
TriCatElisa(Adrenaline/Noradrenaline/Dopamine)Anti-HumanIgMantibody[2B9]
Tricat(Adrenalin,Noradrenalin,Dopamine)ElisaAnti-Cortisolantibody[XM210]
TransglutaminaseScreen,anti-tissueElisaAnti-Cortisolantibody[CORT-2]
TransglutaminaseIgG,anti-tissueAnti-Insulinantibody[3A6]
TransglutaminaseIgA,anti-Anti-Thyroglobulinantibody[5F9]
TransferrinReceptor(sTfR)humanElisa(Soluble)Anti-TCPTPantibody
TRAIL(human)ElisaAnti-ADAM10antibody
TPS(CYK18)(TissuePolypeptideSpecificAg)(Cytokeratin)ElisaAnti-AIFantibody
TPOIgG(ThyroidPeroxidase)Anti-APAF1antibody
TPO(ThyroidPeroxidase)anti-ElisaAnti-APAF1antibody
TPO(ThyroidPeroxidas)Anti-TPOAnti-NOL3antibody
t-PA(human)ElisaAnti-NOL3antibody
SB培养基价格二基基原醇HumanTNFalphaELISPOTKit(withoutplates)
二基异基醇HumanInterferongammaELISPOTKit(withoutplates)
二代赤四醇HumanInterferongammaELISPOTKit(withoutplates)
二氯化三甘醇HumanInterferongammaELISPOTKit(withoutplates)
二胆甾醇HumanInterferongammaELISPOTKit(withoutplates)
二速甾醇Anti-BRD7antibody
二巯基赤藓糖醇HumanIL-2ELISPOTKit
二亚基醇HumanIL-2ELISPOTKit
二基基醇HumanIL-6ELISPOTKit
二二醇HumanIL-6ELISPOTKit
法呢醇HumanIL-10ELISPOTKit
反式-3-己烯-1-醇HumanIL-10ELISPOTKit
佛波醇HumanTNFalphaELISPOTKit
氟哌醇HumanTNFalphaELISPOTKit
钙化醇HumanInterferongammaELISPOTKitZ-DEVD-AMC 20mg
CHURC1血小板源性生长因子A抗体
CRMP3泌素抗体
CRSP9血小板源性生长因子-B抗体
Copine-6血小板源性生长因子受体A抗体(PDGFRα)
Cpt1c血小板源性生长因子受体B抗体(PDGFRβ)
Factor B酸脱酶激酶4抗体
CHRNA1色素上皮源性因子抗体
CSFV Envelope glycoprotein E2肝癌高表达基因抗体
风险提示:丁香通仅作为第三方平台,为商家信息发布提供平台空间。用户咨询产品时请注意保护个人信息及财产安全,合理判断,谨慎选购商品,商家和用户对交易行为负责。对于医疗器械类产品,请先查证核实企业经营资质和医疗器械产品注册证情况。
 文献和实验
文献和实验一、 原理 根据作物无机营养的特点,用作物的必需的矿质元素的培养溶液培养植物,可使植物长到与土壤中一样好,利用此法,所用元素的量可以完全人为控制。因此,要了解某种元素缺乏所引起生理病症,可以从培养液中减去该元素,以便在以后的生育过程中进行观察。通常进行这类实验可用营养液进行“溶液培养”,但根部通气的问题不易解决,“砂基培养”可以较好地解决通气。 二、 设备及药品 1、1000-2000ml的塑料盆;2、塑料杯200-300ml;3、石英砂(约1.5-2毫米直径);4、植物
dingding2004 想找一个药物来阻断SMAD4 的作用。不知有没有做过的。 SMAD4 是在转录水平发挥作用的,如果有这种药物,加在要干预的细胞培养液中,可以发挥作用吗? dingding2004 自己顶下啊 caoying207 唉,没想到2年以后,我也在找SMAD4阻断剂(抑制剂 ),前辈,你找到了吗? skyzhuz 半
2-Mercaptoethanol,5μM DM,10μM SB,10μM Y-27632); 神经分化培养基(主要成分:2% B27,1% GlutaMAX,20 ng/ml hEGF,20 ng/ml hFGF2,20 ng/ml hBDNF,20 ng/ml hNT3) 实验步骤 1、在涂有基质胶的平板上接种 hPSCs 或 iPSCs 细胞,并添加基础培养基进行培养,至出现明显细胞团; 2、将 30-50 个细胞团轻轻重悬于 12 ml 神经诱导培养基中,转移至 10cm 超低附着平板,将这一天记为第 0 天
 技术资料
技术资料暂无技术资料 索取技术资料